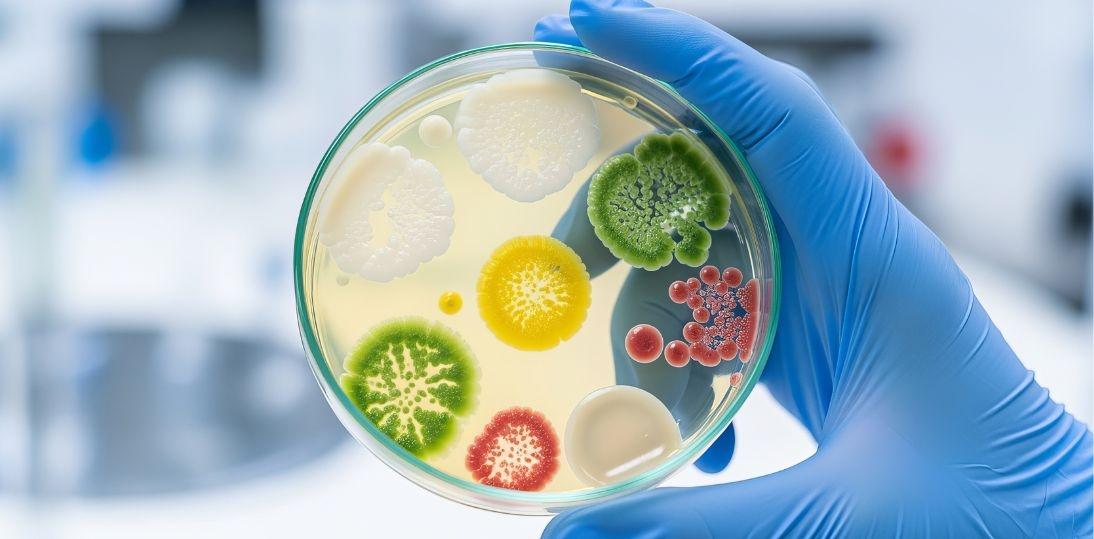
SIBO a alergie. Czy bakterie jelitowe nasilają astmę i choroby atopowe?

SIBO a alergie. Czy bakterie jelitowe nasilają astmę i choroby atopowe?
Opublikowane 02 kwietnia 2026
Alergie zwykle kojarzymy z układem odpornościowym, genetyką i środowiskiem. Coraz częściej jednak w tej układance pojawia się jeszcze jeden element: mikrobiota jelitowa. Przegląd badań opublikowany w czasopiśmie International Journal of Molecular Sciences sugeruje, że przerost bakterii w jelicie cienkim (SIBO) może mieć związek z nasileniem objawów chorób atopowych, takich jak astma oskrzelowa, alergie pokarmowe czy przewlekła pokrzywka.
Praca przeglądowa powstała przy udziale naukowców i studentów Uniwersytetu Medycznego we Wrocławiu, w tym członków Studenckiego Koła Naukowego Alergologii i Chorób Wewnętrznych UMW.
Jelita a układ odpornościowy
SIBO (small intestinal bacterial overgrowth) oznacza nadmierne namnażanie bakterii w jelicie cienkim. Może powodować objawy ze strony przewodu pokarmowego, takie jak wzdęcia, biegunki czy bóle brzucha. Coraz więcej badań wskazuje jednak, że jego skutki mogą wykraczać poza układ trawienny.
Zaburzenia mikrobioty jelitowej mogą wpływać na układ odpornościowy poprzez tzw. oś jelito–odporność. W efekcie dysbioza jelitowa może sprzyjać nasileniu objawów chorób atopowych – dotyczących dróg oddechowych, skóry lub przewodu pokarmowego.
Analiza dostępnych badań pokazuje, że dodatnie wyniki testów oddechowych w kierunku SIBO częściej obserwuje się u pacjentów z astmą oskrzelową, alergiami pokarmowymi, zespołem aktywacji mastocytów oraz przewlekłą pokrzywką spontaniczną. Nie oznacza to jednak, że SIBO jest bezpośrednią przyczyną tych chorób.
- Szacuje się, iż w populacji ogólnej SIBO występuje do ok. 20% osób zdrowych, natomiast dla alergików brak jest jednoznacznych danych. Większość badań wskazuje jednak na korelację między dodatnim wynikiem testu oddechowego a objawami alergii – wyjaśnia dr Krzysztof Gomułka z Katedry i Kliniki Alergologii i Chorób Wewnętrznych UMW. Jak podkreśla badacz, wiele dostępnych danych dotyczy dzieci, dlatego potrzebne są dalsze badania w populacji osób dorosłych.
Kiedy leczenie SIBO może pomóc?
Związek między SIBO a alergiami może mieć znaczenie praktyczne w leczeniu niektórych pacjentów.
- Największa szansa na poprawę objawów po diagnostyce i leczeniu SIBO może dotyczyć pacjentów z astmą oskrzelową, alergiami pokarmowymi oraz przewlekłą pokrzywką spontaniczną – mówi dr Krzysztof Gomułka. Mechanizm tej zależności może działać w obie strony. Z jednej strony SIBO może prowadzić do tzw. „nieszczelności jelita”, która sprzyja stanowi zapalnemu i reakcjom alergicznym. Z drugiej strony przewlekły stan zapalny związany z atopią może zaburzać pracę jelit i sprzyjać namnażaniu bakterii.
Sygnał ostrzegawczy
Diagnostyka w kierunku SIBO nie jest jeszcze standardem u pacjentów z alergią. Są jednak sytuacje, w których warto ją rozważyć.
- Sygnałem ostrzegawczym może być nagłe pogorszenie przebiegu choroby alergicznej lub pojawienie się nowych objawów mimo stosowania dotychczasowego leczenia – podkreśla dr Krzysztof Gomułka. W takich przypadkach konieczna może być dokładniejsza ocena stanu pacjenta i rozszerzenie diagnostyki, w tym w kierunku SIBO.
Nowy kierunek badań nad alergią
Naukowcy podkreślają, że potrzebne są dalsze badania, aby lepiej zrozumieć związek między SIBO a chorobami atopowymi. Jeśli przyszłe wyniki potwierdzą tę zależność, diagnostyka i leczenie zaburzeń mikrobioty jelitowej mogą stać się ważnym elementem terapii części pacjentów z alergiami.
Materiał powstał na podstawie artykułu: International Journal of Molecular Sciences, Possible Crosstalk Between Small Intestinal Bacterial Overgrowth (SIBO) and Atopic Manifestations—A Short Overview, Michał Terlecki, Wiktoria Brzeczek, Martyna Kowalczyk, Emilia Kiełczyńska, Klaudia Kukla, Gabriela Osmulska, Krzysztof Gomułka
Źródło: Komunikat Prasowy
Jelita a układ odpornościowy
SIBO (small intestinal bacterial overgrowth) oznacza nadmierne namnażanie bakterii w jelicie cienkim. Może powodować objawy ze strony przewodu pokarmowego, takie jak wzdęcia, biegunki czy bóle brzucha. Coraz więcej badań wskazuje jednak, że jego skutki mogą wykraczać poza układ trawienny.
Zaburzenia mikrobioty jelitowej mogą wpływać na układ odpornościowy poprzez tzw. oś jelito–odporność. W efekcie dysbioza jelitowa może sprzyjać nasileniu objawów chorób atopowych – dotyczących dróg oddechowych, skóry lub przewodu pokarmowego.
Analiza dostępnych badań pokazuje, że dodatnie wyniki testów oddechowych w kierunku SIBO częściej obserwuje się u pacjentów z astmą oskrzelową, alergiami pokarmowymi, zespołem aktywacji mastocytów oraz przewlekłą pokrzywką spontaniczną. Nie oznacza to jednak, że SIBO jest bezpośrednią przyczyną tych chorób.
- Szacuje się, iż w populacji ogólnej SIBO występuje do ok. 20% osób zdrowych, natomiast dla alergików brak jest jednoznacznych danych. Większość badań wskazuje jednak na korelację między dodatnim wynikiem testu oddechowego a objawami alergii – wyjaśnia dr Krzysztof Gomułka z Katedry i Kliniki Alergologii i Chorób Wewnętrznych UMW. Jak podkreśla badacz, wiele dostępnych danych dotyczy dzieci, dlatego potrzebne są dalsze badania w populacji osób dorosłych.
Kiedy leczenie SIBO może pomóc?
Związek między SIBO a alergiami może mieć znaczenie praktyczne w leczeniu niektórych pacjentów.
- Największa szansa na poprawę objawów po diagnostyce i leczeniu SIBO może dotyczyć pacjentów z astmą oskrzelową, alergiami pokarmowymi oraz przewlekłą pokrzywką spontaniczną – mówi dr Krzysztof Gomułka. Mechanizm tej zależności może działać w obie strony. Z jednej strony SIBO może prowadzić do tzw. „nieszczelności jelita”, która sprzyja stanowi zapalnemu i reakcjom alergicznym. Z drugiej strony przewlekły stan zapalny związany z atopią może zaburzać pracę jelit i sprzyjać namnażaniu bakterii.
Sygnał ostrzegawczy
Diagnostyka w kierunku SIBO nie jest jeszcze standardem u pacjentów z alergią. Są jednak sytuacje, w których warto ją rozważyć.
- Sygnałem ostrzegawczym może być nagłe pogorszenie przebiegu choroby alergicznej lub pojawienie się nowych objawów mimo stosowania dotychczasowego leczenia – podkreśla dr Krzysztof Gomułka. W takich przypadkach konieczna może być dokładniejsza ocena stanu pacjenta i rozszerzenie diagnostyki, w tym w kierunku SIBO.
Nowy kierunek badań nad alergią
Naukowcy podkreślają, że potrzebne są dalsze badania, aby lepiej zrozumieć związek między SIBO a chorobami atopowymi. Jeśli przyszłe wyniki potwierdzą tę zależność, diagnostyka i leczenie zaburzeń mikrobioty jelitowej mogą stać się ważnym elementem terapii części pacjentów z alergiami.
Materiał powstał na podstawie artykułu: International Journal of Molecular Sciences, Possible Crosstalk Between Small Intestinal Bacterial Overgrowth (SIBO) and Atopic Manifestations—A Short Overview, Michał Terlecki, Wiktoria Brzeczek, Martyna Kowalczyk, Emilia Kiełczyńska, Klaudia Kukla, Gabriela Osmulska, Krzysztof Gomułka
Źródło: Komunikat Prasowy
Autor:
Redakcja MedicalPress
